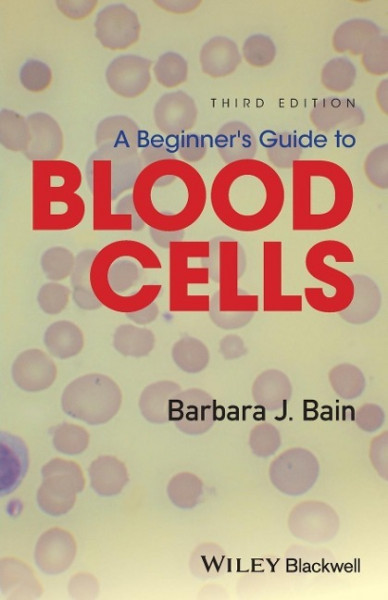
BEGINNERS GT BLOOD CELLS 3/E

BEGINNERS GT BLOOD CELLS 3/E
Kurzinformation
inkl. MwSt. Versandinformationen
Artikel zZt. nicht lieferbar
Artikel zZt. nicht lieferbar

Beschreibung
The third edition of this popular pocket book, A Beginner's Guide to Blood Cells written by Professor Barbara Bain, provides a concise introduction to normal and abnormal blood cells and blood counts for trainees in haematology. * Includes a brand new chapter on emergency morphology, designed to make the clinical significance and urgency of certain laboratory findings clear for biomedical scientists and to assist trainee haematologists in the recognition of major clinically important abnormalities * Contains exceptional full colour images throughout * Introduces important basic concepts of hematology, setting haematological findings in a clinical context * Provides a fully updated self-assessment section * An essential resource for trainee haematologists, biomedical scientists, and biomedical science and medical students von Bain, Barbara J.
Produktdetails

So garantieren wir Dir zu jeder Zeit Premiumqualität.
Über den Autor

- paperback
- 496 Seiten
- Erschienen 1985
- MIT Press

- perfect -
- Stuttgart : Thieme

- paperback
- 120 Seiten
- Deutscher Ärzteverlag

- Kartoniert
- 864 Seiten
- Erschienen 2016
- Garland Publishing Inc

- Hardcover
- 404 Seiten
- -

- Gebunden
- 162 Seiten
- Erschienen 2015
- Semmelweis-Institut

- hardcover
- 369 Seiten
- Erschienen 2001
- Academic Press

- Kartoniert
- 338 Seiten
- Erschienen 2021
- Deutscher Ärzteverlag

- hardcover -
- Erschienen 1900
- FisicalBook

- hardcover
- 440 Seiten
- Erschienen 1985
- Springer

- perfect
- 200 Seiten
- Erschienen 2025
- Hogrefe AG

- Hardcover
- 135 Seiten
- Erschienen 2006
- Urban & Fischer Verlag/Else...

- Kartoniert
- 1464 Seiten
- Erschienen 2015
- Taylor & Francis

- Hardcover -
- Erschienen 2010
- Urban & Fischer Verlag/Else...

- Hardcover
- 298 Seiten
- Erschienen 2013
- Thieme






























